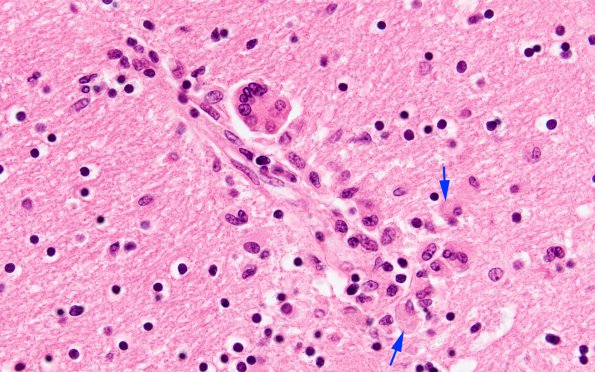
1C5 HIVE & HIVL, fulminant (Case 1) N1A H&E 3 copy

Table of Contents
Washington University Experience | INFECTION | Viruses | HIV | HIV Encephalitis | 1C5 HIVE & HIVL, fulminant (Case 1) N1A H&E 3 copy
Histiocytes which accompany multinucleate giant cells often accumulate a significant amount of cytoplasm (arrows, H&E)